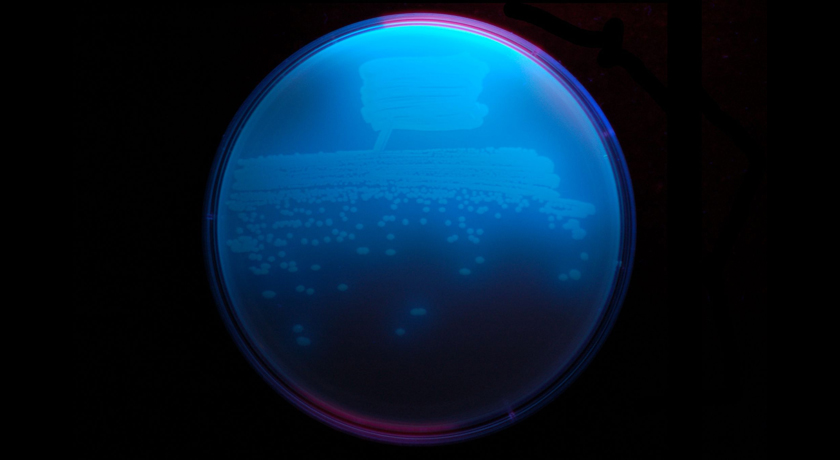
Pseudomonas fluorescens

Superfast evolution observed in soil bacteria
Two mutations allowed soil bacteria (Pseudomonas fluorescens) to re-evolve flagella: One pumped up levels of a protein than controls nitrogen uptake, and one that switched that protein’s job to flagella production control.
Ninjatacoshell/Wikimedia Commons (CC BY-SA 3.0)






